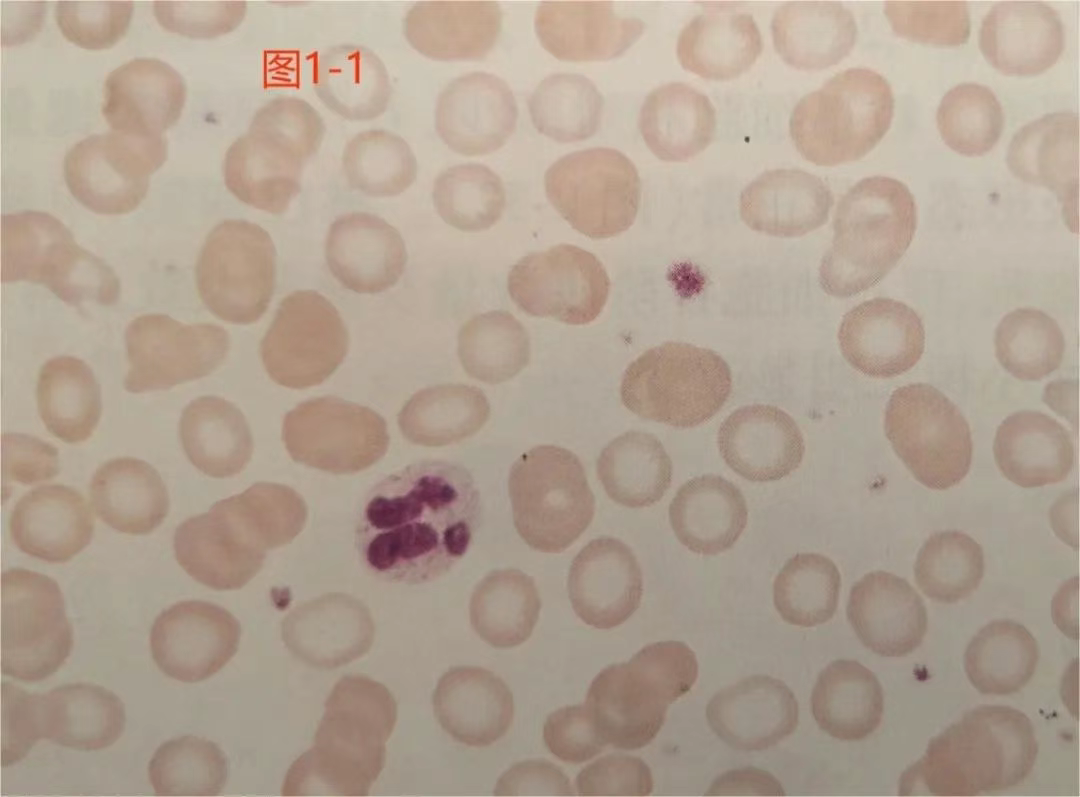
wuwei

疲惫苍白?贫血在报警!
疲惫苍白?贫血在报警!
当你总感觉身体被掏空、面色苍白如纸,可能不是劳累过度——而是血液中的"铁元素"正在悄悄流失!

一、缺铁性贫血:身体里的“氧气危机”
首先,我们先回顾一下贫血概念。贫血是指人体外周血红细胞容量减少,血红蛋白浓度低于正常,导致组织器官缺氧的一种常见的临床症状。
国内贫血诊断标准为:在我国海平面地区,成年男性血红蛋白<120g/L,成年女性(非妊娠)血红蛋白<110g/L,孕妇血红蛋白<100g/L。

什么是缺铁性贫血?简单来说,铁是制造血红蛋白的 "原材料",而血红蛋白就像血液里的 "氧气运输队"。当体内铁不够时,血红蛋白造得少,血液运输氧气能力下降,全身器官就会像 "缺粮的军队" 一样没劲儿,这就是缺铁性贫血。
二、身体发出的缺氧警报(缺铁性贫血常见症状)
1.贫血表现:主要是人体器官缺氧的症状

2.缺铁表现:如异食癖比如吃土、指甲、口腔炎、舌炎、匙状指(指甲变平甚至凹下成勺状)等

三、铁元素去哪了?三大流失黑洞
1.铁摄入不足:婴幼儿不及时添加蛋类、肉类等含铁量较高的辅食,青少年偏食,妊娠或哺乳、导致需铁量增加又没有及时补充。
2.铁吸收障碍:各种肠道疾病容易导致铁的吸收障碍。
3.铁丢失过多:长期慢性铁丢失又得不到纠正,比如胃肠道疾病中的痔疮、胃十二指肠溃疡、息肉、肿瘤、女性月经丢失过多,妇科疾病中的子宫肌瘤等。
四、科学补铁:不是吃够就行!
1.治疗原则:“根除病因,不足铁量”
①病因治疗:
- 月经过多者需接受妇科治疗,调整月经周期或控制出血量
- 肿瘤患者需化疗、放疗或手术治疗,并注意患者的营养支持
- 儿童、妊娠妇女因营养不足引起的贫血,应改善饮食,营养支持,纠正偏食的不良习惯
- 消化性溃疡引起者应抑酸治疗,减轻黏膜出血。
②补铁治疗:
- 补铁首选口服铁:如硫酸亚铁、右旋糖酐铁、维铁缓释片、琥珀酸亚铁等
- 如果不能耐受口服铁剂,可以肌注铁剂补充,还可以静脉补铁,最常用的注射铁剂是右旋糖酐铁
五、预防缺铁性贫血:从现在做起
1.均衡饮食:增加富含铁的食物,如红肉、禽类、鱼类、豆类、坚果、全谷物和绿叶蔬菜。
2.搭配维生素C:同时摄入富含维生素C的食物,如橙子、草莓、西红柿等,可以提高铁的吸收率。
3.避免干扰物:饮用茶、咖啡和含钙食品时要注意与富含铁的食物分开食用,避免影响铁的吸收。
4.定期检查:定期进行血液检查,监测铁水平,特别是对于孕妇、月经量多的女性和儿童。
5.适量补充:在医生指导下,必要时补充铁剂,补足量但注意不要过量。
